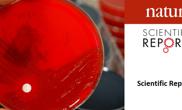
Streptococcus B

Stuðul til eina verkætlan?
Síggj møguleikar og freistir á umsóknarportalinumHorizon Europe
Vit kunna og vegleiða um møguleikarTørvar tær eitt sterkari netverk?
Í COST Actions eru nógvir samstarvsmøguleikarÚt í heim at granska?
Á euraxess.fo fært tú góð ráð og vegleiðing við á vegnumFeskastu granskingarúrslitini
Leita eftir vísindaligum útgávum og sambondum